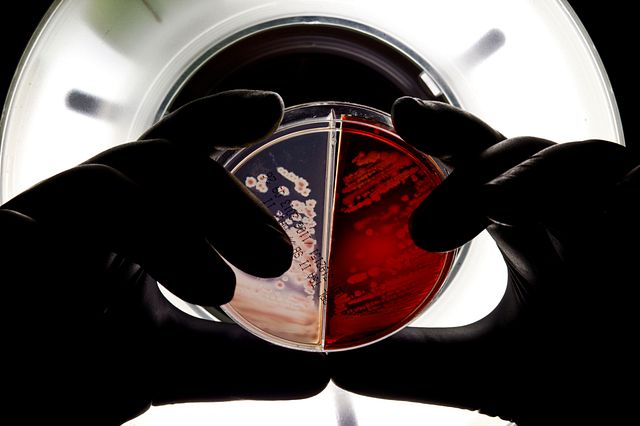

Cosmetic, OTC, and Personal Care Product Compliance Solutions
Celsis® Rapid Microbiology Detection
Celsis® rapid microbiology detection has been validated and demonstrated as an alternative rapid method to replace compendial testing. The equivalency of our rapid microbial method to the traditional pore plate testing method has allowed some of the largest manufacturers to implement Celsis in their quality control processes globally and across several sites.
Learn More
Accugenix® Microbial Identification
With the Accugenix® microbial identification service 21 CFR Part 11* compliant environmental monitoring tools, users can import and export organism data with detailed records of identified species, frequency of occurrence, and other aggregated information for analysis.
Learn More
*21 CFR Part 11 is a code of federal regulations to comply with FDA mandates and streamline processes to facilitate effective management of document control, change control, training control, audits, CAPA, customer complaints, and all other quality business processes.
Reach out to our Cosmetic Regulatory Compliance team to discuss how we can assist you.
Common Personal Care and Cosmetic Regulatory Compliance Guidelines
The first step of compliance for manufacturers is to understand the regulatory requirements that apply to your products in the countries where you sell them, including safety, labeling, and ingredient disclosure requirements.
There are several countries that have cosmetic regulatory compliance agencies such as the FDA in the US, EMA in Europe, The Association of Southeast Asian Nations, or ASEAN Cosmetic Directive to name a few. For more information on common microbial guidelines that have been accepted by these agencies, refer to the list below.
-
USP and ISO Standards
USP <60> Microbiological Examination of Non-Sterile Products Tests for Burkholderia cepacia (B. cepacia) Complex USP <61> Microbiological Examination of Nonsterile Products: Microbial Enumeration Tests USP <62> Microbiological Examination of Nonsterile Products: Tests for Specified Microorganisms USP <1223> Validation of Alternative Microbiological Methods ISO 16212 Cosmetics – Microbiology – Enumeration of Yeast and Mold ISO 18415 Cosmetics – Microbiology – Detection of Specified and Non-Specified Microorganisms ISO 18416 Cosmetics – Microbiology – Detection of Candida albicans ISO 21149 Cosmetics – Microbiology – Enumeration and Detection of Aerobic Mesophilic Bacteria ISO 21150 Cosmetics – Microbiology – Detection of Escherichia coli ISO 22716 Cosmetics – Good Manufacturing Practices (GMP) – Guidelines on Good Manufacturing Practices ISO 22717 Cosmetics – Microbiology – Detection of Pseudomonas aeruginosa ISO 22718 Cosmetics – Microbiology – Detection of Staphylococcus aureus
OTC Drug Products Regulatory Guidance
More and more personal care products are being classified as OTC products bringing increased regulatory oversight and requiring companies to adopt GMP and pharmaceutical level quality control standards. OTC products have different regulatory requirements involving increased testing and method validation than traditional cosmetic and personal care products.
Our ISO Accreditation and Certifications for Personal Care Product Compliance
In order to achieve personal care, OTC, and cosmetic regulatory compliance with internationally recognized standards, you need to be certain that you work with a partner that does the same. To help you achieve that level of confidence, Charles River has a corporate compliance program that assures clients, management, regulatory authorities, and staff meet expectations and ISO accreditations.
MicroLearning Series for Home and Personal Care
Expand your knowledge on the fundamentals of microbiology specific to the importance of microbial detection and identification to ensure product quality.
Watch Now
Frequently Asked Questions about Cosmetic Regulatory Compliance
-
What classifies an OTC?
Cosmetic products may be regulated as OTC drug products when they contain active ingredients and are intended for uses that alter the structure or function of the body, or prevent, treat, or mitigate disease. OTC products are those that can be used appropriately by consumers for self-limiting disease conditions amenable to self-diagnosis (of symptoms) and treatment as described by local regulators.
The following products must comply with regulations and requirements for both cosmetics and OTC drugs:
- Sunscreens
- Antiperspirants
- Anti-dandruff
- Acne solutions
- Toothpastes containing fluoride
OTC drug products may also be subject to specific regulations depending on their intended uses. For example, OTC sunscreens must meet the FDA's requirements for Broad Spectrum SPF and water resistance. Some countries have additional OTC drug and cosmetic regulatory compliance requirements. Another example, Japan requires that all OTC cosmetic products be registered with the government before they can be sold.
-
What are the current Good Manufacturing Practices (GMP)?
Regulatory agencies are changing their requirements regarding current Good Manufacturing Practices (GMP). GMP’s are quality control standards that align with regulatory demands. It provides guidelines for quality manufacturing of products through standardized procedures and regular oversight of facilities, records, staff, industrial hygiene, and overall operations. For more details refer to ISO22716 Cosmetics GMP Guideline.
The Micro Keeps You in The Know
You don't need an agar plate to grow your microbial knowledge. Get industry updates, articles and other resources delivered straight to your inbox each month.
Subscribe